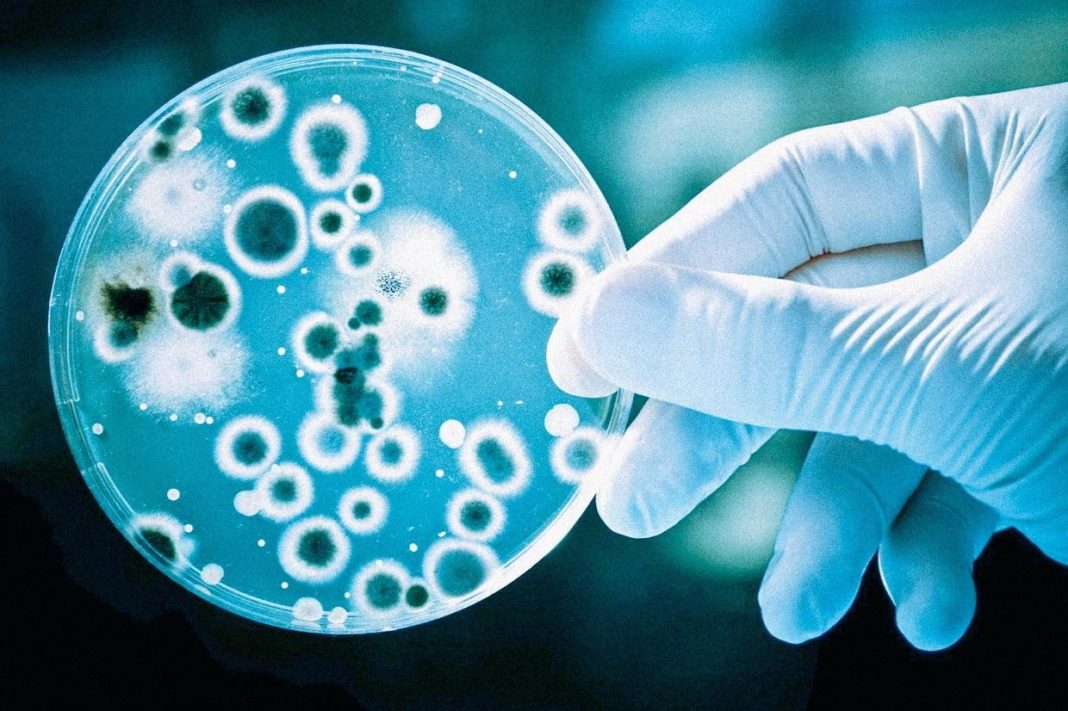

As superbactérias estão virando uma dor de cabeça no ambiente hospitalar na Bahia. No ano de 2018 oito pessoas por dia, em média, foram afetadas por algum tipo de superbactéria no estado, de acordo com o portal Correio. Em comparativo com o ano de 2013, o número de casos de contaminação cresceu três vezes mais. Os dados são da Secretaria de Saúde da Bahia (Sesab).
A pasta, que é responsável pelo monitoramento dos casos de contaminação, obriga desde 2010 a notificação dos hospitais a cada caso de paciente atingido pelos micro-organismos específicos. Na Bahia, o comportamento de 13 tipos destas superbactérias estão sendo acompanhados.
Segundo a Organização Mundial da Saúde (OMS), conforme dados de 2016, 700 mil pessoas estavam morrendo vítimas das superbactérias a cada ano.
O órgão, inclusive, faz um alerta. Se medidas eficazes para deter o aumento desses micro-organismos não forem implementadas, é previsto que em 2050 10 milhões de pessoas em todo planeta vão morrer por conta da contaminação destes seres-vivos resistentes.
Fonte: Bahia Notícias